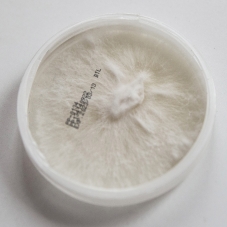

Čistá kultura Housenice červené mycelium na agarovém médiu. Je vhodná pro roubování obilí za účelem získání tzv granulované mycelium nebo pro další klonování na agaru.
Průměr Petriho misky - 90 mm výška - 15 mm Mycelium lze skladovat maximálně 3-6 měsíců při teplotě 1-5°C.
Husenice červená (Cordyceps militaris) je v přírodě velmi vzácná. Jejím přirozeným prostředím je Tibetská náhorní plošina. V zimě parazituje na larvách hmyzu, které jsou pod zemí. Podhoubí vyplouvá na povrch v létě. Oranžová plodová tělíska nejsou větší než palec dospělého člověka. Jde o unikátní houbu s příznivým vlivem na celkový stav celého organismu.
Mezi mnoha cennými zdraví prospěšnými vlastnostmi Cordycepsu mimo jiné:
• snižuje hladinu stresu
• stimuluje imunitní systém
• posiluje kondici
• zvyšuje hladinu libida
• odstraňuje únavu
• stimuluje metabolismus